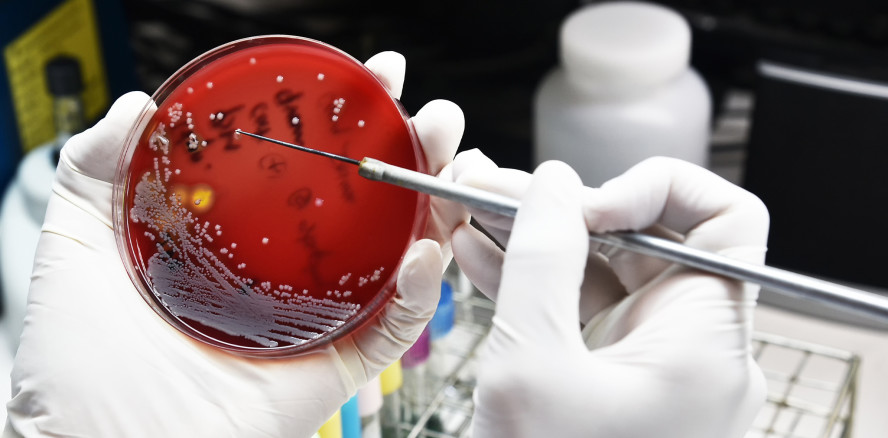
Tödliche Antibiotikaresistenzen nehmen zu

Branchenmeldungen 24.10.2022
Tödliche Antibiotikaresistenzen nehmen zu
Eine im Fachmagazin The Lancet publizierte Studie der WHO zeigt, dass Infektionen mit antibiotikaresistenten Bakterien (AMR) global nach Herz-Kreislauf-Erkrankungen und Krebs zu den häufigsten Todesursachen gehören.
Auf der Grundlage der umfangreichen Analyse gab es 2019 schätzungsweise 4,95 Millionen Todesfälle, die im Zusammenhang mit einer bakteriellen Antibiotikaresistenz standen. 1,27 Millionen Todesfälle sind direkt auf eine bakterielle Antibiotikaresistenz zurückzuführen. Folglich sind arzneimittelresistente Infektionen für mehr Todesfälle verantwortlich als Malaria und Aids.
Umfassende Daten
Die Studie ist die bisher umfassendste Analyse der AMR-Belastung und liefert Schätzungen für 204 Länder und Gebiete, 23 bakterielle Krankheitserreger und 88 ErregerWirkstoff-Kombinationen im Jahr 2019. Sie nutzt unter anderem Informationen aus der 2019 erschienenen Global Burden of Diseases, Injuries and Risk Factors Study (GBD).
Infektionsbedingte Todesfälle
Die umfangreichen Daten ermöglichten es den Autoren, die Anzahl der Todesfälle durch Infektionen mit multiresistenten Bakterien zu beurteilen. Auch konnten die Wissenschaftler die Todesfälle einzelnen Bakterien zuordnen.
Die sechs häufigsten Krankheitserreger für resistenzbedingte Todesfälle sind Escherichia coli, gefolgt von Staphylococcus aureus, Klebsiella pneumoniae, Streptococcus pneumoniae, Acinetobacter baumannii und Pseudomonas aeruginosa. Diese Mikroorganismen sind für fast drei Viertel aller Todesfälle verantwortlich.
Weiter zeigt die Studie, dass in Regionen mit einem hohen Einkommen Streptococcus aureus und Escherichia coli für etwa die Hälfte der Todesfälle verantwortlich sind. In armen Regionen wie z. B. in Afrika verursachten Streptococcus pneumoniae und Klebsiella pneumoniae die meisten Todesfälle.
Quelle: The Lancet
Dieser Beitrag ist in der Dental Tribune Schweiz erschienen.